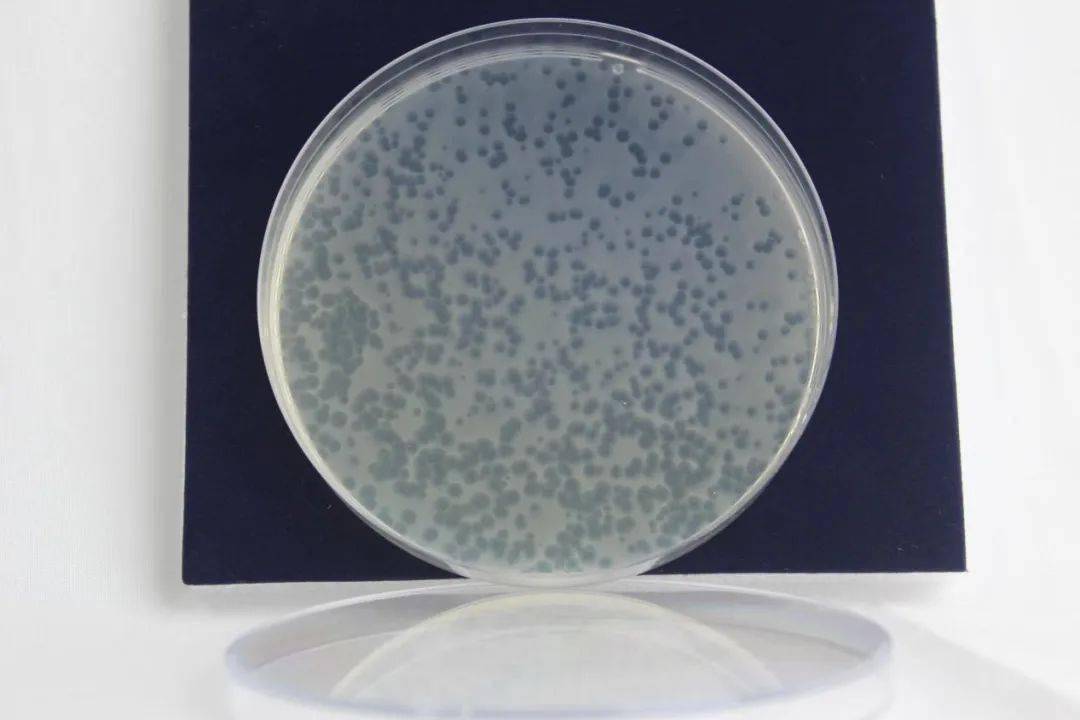
除了副溶血弧菌以外,针对哈维氏弧菌,溶藻弧菌,我们都陆续推出了相应
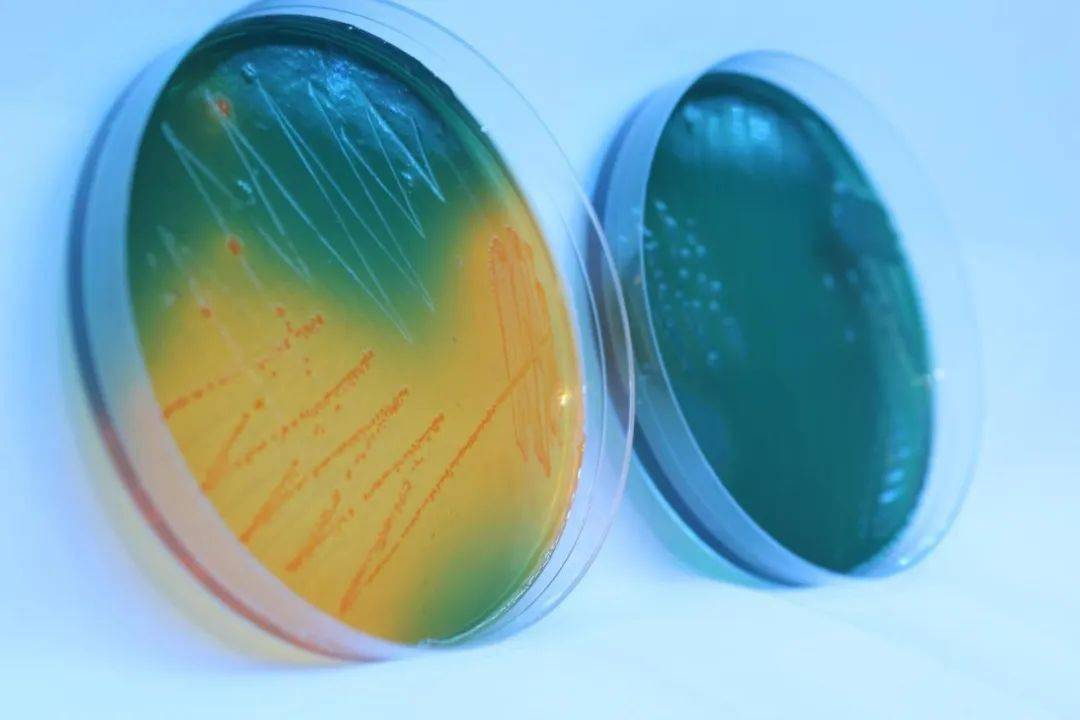
除了副溶血弧菌以外,针对哈维氏弧菌,溶藻弧菌,我们都陆续推出了相应

哈维弧菌

弧菌不可怕!_对虾_池塘_菌落
图片尺寸997x487
哈维氏弧菌感染的症状,死虾在夜间会发光,值得注意的是这种发光不是在
图片尺寸435x240
哈维氏弧菌按照方法活化活化不成功
图片尺寸1080x1440
虾的主要致菌为:溶藻弧菌,副溶血弧菌,哈维氏弧菌,霍乱弧菌等.
图片尺寸1080x1920
弧菌
图片尺寸756x504
88底舒宝对哈维氏弧菌的抑制效果缓释增氧,高效持久88通过吹气球
图片尺寸692x347
三种弧菌影响南美白对虾的健康分别是:副溶血弧菌,溶藻弧菌,哈维弧菌
图片尺寸1080x722
一株致病性海洋哈氏弧菌及其应用的制作方法
图片尺寸973x1000
哈维氏弧菌说明
图片尺寸500x500
史上最短命论文配图辣眼睛顶尖985医院院长论文发表后三天被撤稿
图片尺寸577x816
乾界生物给您解答 绿弧菌就是哈维氏弧菌:使南美白对虾患荧光病,发病
图片尺寸1280x1275
令养殖户一直头疼的有害菌——弧菌,到底该如何搞定
图片尺寸640x594
夏天高温肠炎白便爆发把弧菌赶尽杀绝才安心
图片尺寸1080x1440
弧菌是一种条件致病菌,在正常的养殖池塘中也是有弧菌存在的,也就是说
图片尺寸641x472
除了副溶血弧菌以外,针对哈维氏弧菌,溶藻弧菌,我们都陆续推出了相应
图片尺寸1080x720
除了副溶血弧菌以外,针对哈维氏弧菌,溶藻弧菌,我们都陆续推出了相应
图片尺寸1080x720
日志
图片尺寸1800x1350
哈维弧菌与发光细菌疾病有关,鳗弧菌是攻击幼虾并导致大量死亡的主要
图片尺寸588x670
肠炎,白便,玻璃苗)多多少少都与弧菌(溶藻弧菌,哈维氏弧菌,副溶血弧菌
图片尺寸1280x1374
弧菌知识360度详解不容错过
图片尺寸640x422